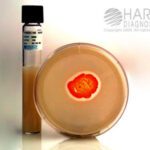
Nocardia Hydrolysis Kit for Actinomycetes, Hardy Diagnostics - Z604, 20 x 125 mm, Nocardia Hydrolysis Kit, HDx

Accessories for BD Veritor Systems, BD Diagnostics – 256066, Veritor plus analyzer
SKU:
ASR-256066-EA
Restricted Status
PLUS ANALYZER VERITOR PRINT-ENABLE TO PC
$382.72 Commercial Only
Shipping
Authorities in our business will tell in no uncertain terms that Lorem Ipsum is that huge, huge no no to forswear forever. Not so fast, I'd say, there are some redeeming factors in favor of greeking text, as its use is merely the symptom of a worse problem to take into consideration.
Product details
PLUS ANALYZER VERITOR PRINT-ENABLE TO PC
| Brand | BD |
|---|---|
| Manufacturer | BD |
| Product Size | 1 item |
| Size / Quantity | 1-EA |
Description
Size quantity : 1-EA
Description : Veritor Plus Analyzer, Instrument to analyze BD Veritor test devices, Enable in Analyze Now or Walk-Away modes, Print-enabledand download to a PC
Related Products
Commercial Only
$172.02 Commercial Only
Commercial Only
$95.23 Commercial Only
Commercial Only
$264.55 Commercial Only
Commercial Only
$128.86 Commercial Only
Commercial Only
$657.11 Commercial Only
Commercial Only
$53.71 Commercial Only
Commercial Only
$41.84 Commercial Only
Commercial Only
$125.62 Commercial Only
Commercial Only
$324.19 Commercial Only
Commercial Only
$85.01 Commercial Only
Commercial Only
$68.77 Commercial Only